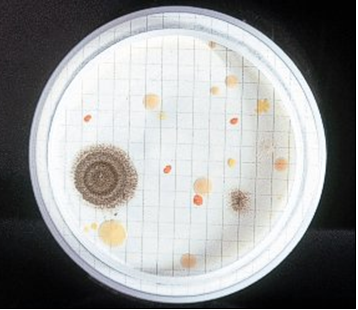
Recuento total por filtración de membrana en un agua destilada: Gran recuperación y diversidad de flora mixta.
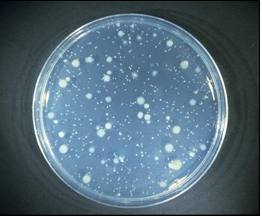
Recuento total por siembra en masa.
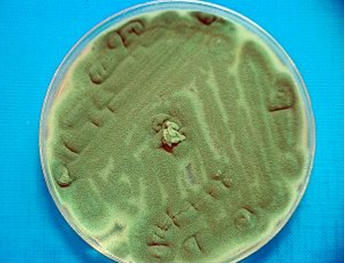
Aspergillus fumigatus, patógeno oportunista, en PDA
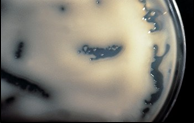
Cryptococcus neoformans, patógeno humano
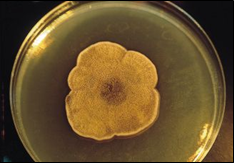
Alternaria alternata, patógena de claveles, alergénica

Agar Rosa Bengala Cloranfenicol: Recuento Óptimo de Hongos
Aspergillus flavus aflatoxigénico (amarillo), Aspergillus fumigatus, grave patógeno oportunista (verde), y otros hongos y levaduras de crecimiento lento que en otros medios no serían capaces de crecer.
Este medio de cultivo selectivo ha sido optimizado para proporcionar la máxima recuperación de levaduras y mohos (L & M), permitiendo obtener recuentos más reales y elevados. Es el medio normalizado para el control de mohos y levaduras en aire y superficies, conforme a la Norma UNE 100012:2005.
1. Características y Principio de Acción
El Agar Rosa Bengala Cloranfenicol es una herramienta esencial en la micología de control de calidad.
- Selectividad Mejorada: El Cloranfenicol, un antibacteriano de amplio espectro, inhibe el crecimiento de las bacterias acompañantes, asegurando que solo los hongos se desarrollen.
- Recuperación Máxima: Gracias a su pH neutro, las células y esporas de hongos que pudieran estar dañadas crecen sin dificultad, lo que se traduce en una magnífica tasa de recuperación.
- Control de Crecimiento: El colorante Rosa de Bengala actúa limitando la invasión de la placa por mohos de crecimiento rápido, facilitando el recuento de colonias individuales. Este factor es crucial para visualizar hongos de crecimiento lento que, en otros medios, serían superados y no crecerían, como se aprecia en colonias de Aspergillus flavus o Aspergillus fumigatus.
2. Composición Nutricional
La formulación incluye una Polipeptona Micológica que, junto con la glucosa, asegura un aporte nutricional idóneo para el desarrollo de la flora fúngica.
| Componente | Cantidad por Litro (g) |
| Polipeptona Micológica | 5.00 g |
| Glucosa | 10.00 g |
| Agar-agar | 15.00 g |
| Fosfato Potásico | 1.00 g |
| Sulfato de Magnesio | 0.50 g |
| Cloranfenicol | 0.20 g |
| Rosa de Bengala | 0.06 g |
Fórmula por Litro: pH final: 7.2 +/- 0.2
3. Preparación y Conservación
Preparación del Medio Deshidratado
- Disolución: Disuelva 32 g del medio deshidratado en 1 litro de agua destilada.
- Ebullición: Caliente la mezcla agitando hasta que alcance el punto de ebullición para lograr la disolución total.
- Esterilización: Autoclave a 121 °C durante 15 minutos.
- Para Uso Exclusivo en Laboratorio.
- Almacenamiento: Mantenga el bote bien cerrado en un lugar seco, fresco y oscuro. Agite el bote antes de usarlo.
4. Control de Calidad y Rendimiento
El medio deshidratado se presenta como un Polvo grueso de color Rosa, que se mantiene como Rosa Estéril una vez preparado.
Evaluación del Rendimiento (3-5 días a 25 °C):
| Cepa de Referencia | Resultado | Descripción de Colonia | Productividad Relativa (PR>0.5) |
| Aspergillus niger 16404 | Crecimiento Correcto | Colonias algodonosas, amarillas en 3 días, negras en 5. | 73-107% de recuperación |
| Candida albicans 10231 | Crecimiento Correcto | Colonias lisas, pastosas y abultadas (rosas o blancas). | 107-248% de recuperación |
| Saccharomyces cerevisiae 9763 | Crecimiento Correcto | Colonias rosas o blancas. | 55-126% de recuperación |
| Penicillium aurantiogriseum 1250 | Crecimiento Correcto | – | 50-150% de recuperación |
| Escherichia coli 25922 | Inhibición Total | No se observa crecimiento de colonias. | – |
| Bacillus subtilis 6633 | Inhibición Total | No se observa crecimiento de colonias. | – |
5. Protocolo de Siembra e Interpretación
Siembra
Es esencial incubar las placas a 22 °C aproximadamente, durante 3 a 5 días, y hacerlo en total oscuridad. La luz intensa puede volver al Rosa Bengala inhibitorio.
- Siembra en Superficie: Siembre 0.1 mL de la muestra (o su dilución) y extienda con un triángulo de vidrio (asa Digralsky). Este método es ideal para el recuento máximo de mohos, que son microorganismos muy aerófilos.
- Siembra en Masa: Para el recuento de levaduras, el método en masa suele ofrecer mejores resultados dada su capacidad fermentativa, aunque algunas como Candida albicans crecen más rápido y más exhuberantes en superficie.
- Recomendación Óptima: Para obtener el recuento más preciso de ambos grupos, se sugiere realizar una siembra duplicada (una placa en masa y otra en superficie).
- Control Ambiental: Las Placas de Contacto se aplican directamente sobre superficies o se utilizan en muestreadores de aire.
Interpretación
- Recuento: Cuente todas las colonias desarrolladas: las colonias filamentosas se identifican como mohos, y las colonias no filamentosas, lisas y pastosas, como levaduras.
- Eliminación: El usuario final es el único responsable de la eliminación de los microorganismos desarrollados, conforme a la legislación medioambiental vigente. Recuerde autoclavar el medio antes de desecharlo.
Presentación del Producto
Aspergillus fumigatus,
“el terror de los quirófanos”

Alternaria alternata (aún sin esporular) vista desde abajo (izda.) y desde arriba (dcha.) en Rosa Bengala Caf.Agar

Hasta los mohos estoloníferos como el del pan, Rhizopus nigricans, que aparece en la foto con su típico “césped”, pueden ser fácilmente enumerados en el Rosa Bengala Caf.Agar de MICROKIT:
Rosa Bengala Cloranfenicol Agar: medio optimizado para obtener recuentos más reales (más elevados) de levaduras y mohos
https://www.microkit.es/fichas/ROSA-BENGALA-CLORANFENICOL-AGAR.pdf
Si desea más información y precios actualizados sobre nuestro ROSA BENGALA CLORANFENICOL AGAR póngase en contacto con nosotros a través de nuestro correo electrónico microkit@microkit.es o por teléfono en el nº 91-897 46 16
https://www.microkit.es/monograficos/4-Levaduras-y-mohos-monograf–a.pdf